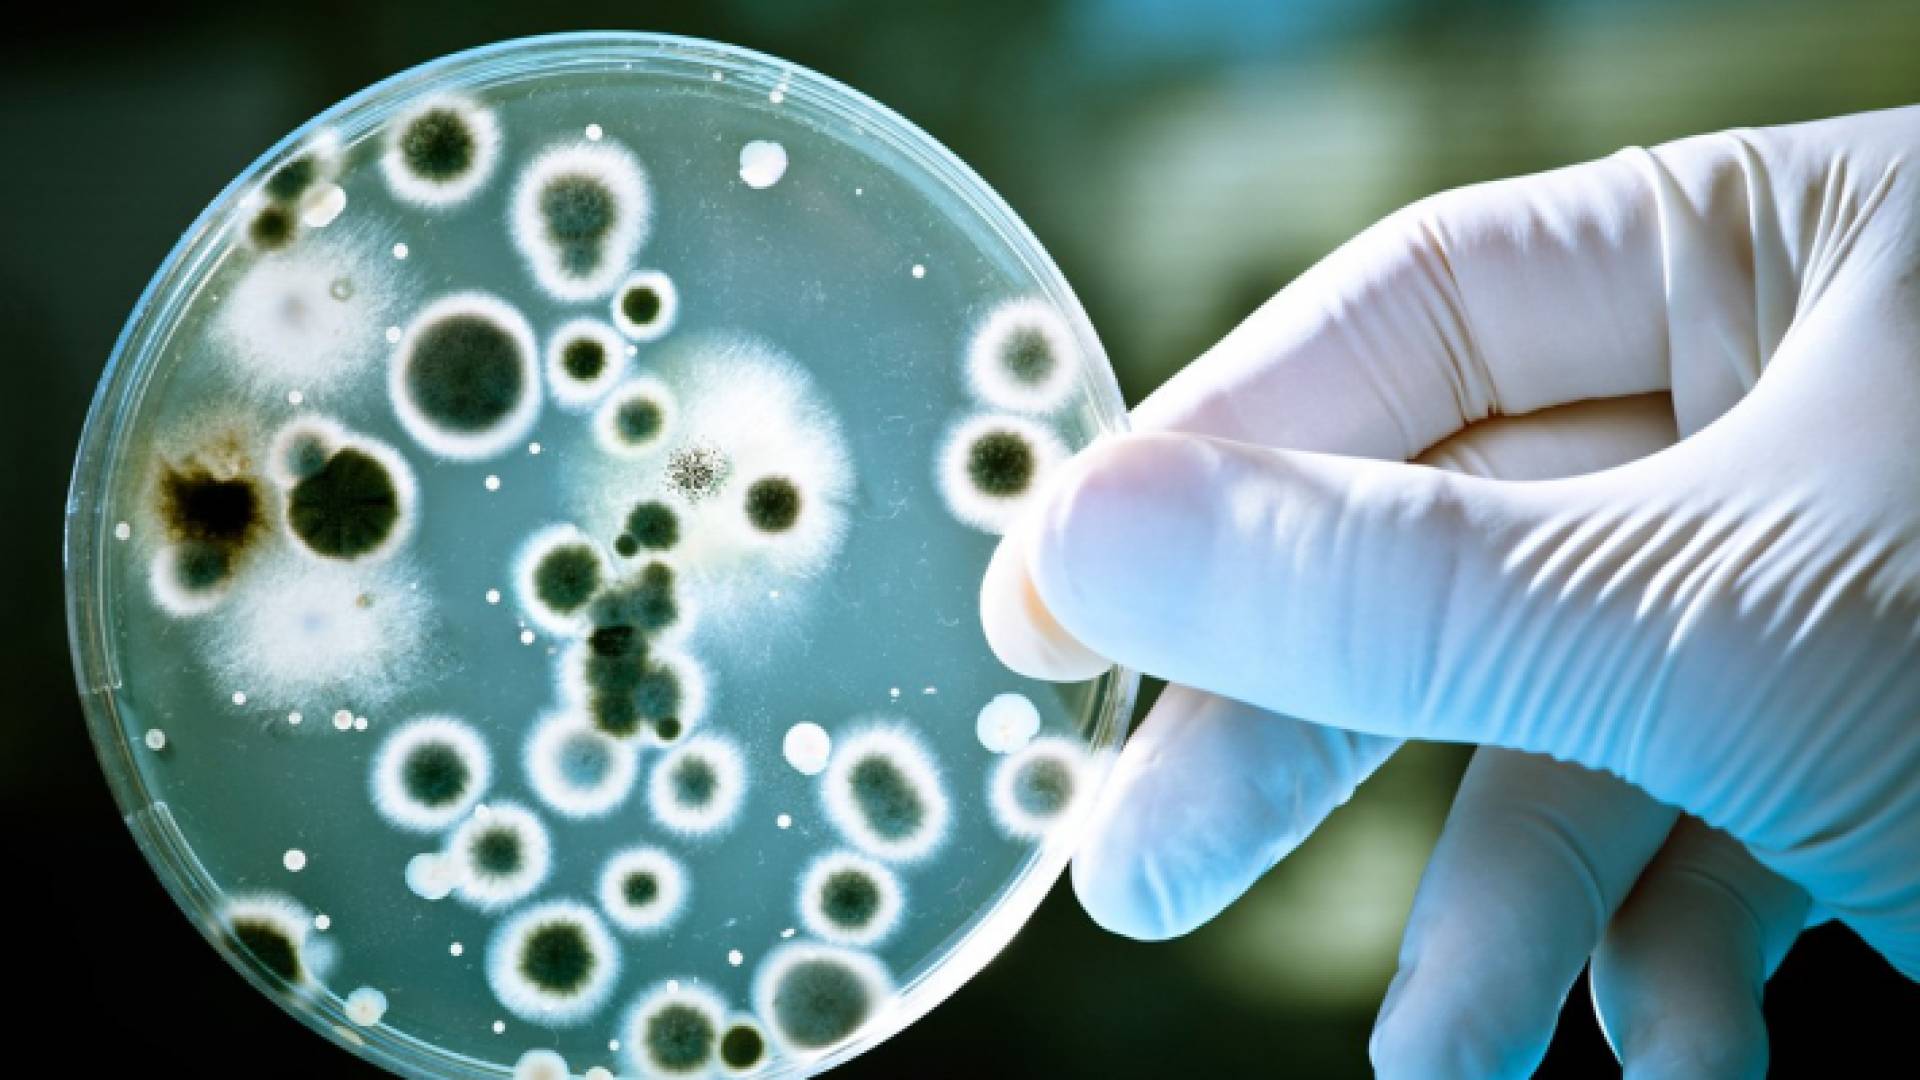
أحد أنواع البكتيريا

أحد أنواع البكتيريا
الطراونة لرؤيا: الوفاة بسبب جرثومة "شيغيلا" نادرة الحدوث - فيديو
قال اختصاصي الأمراض الداخلية والميكروبات، الدكتور فراس الطراونة، إن جرثومة "شيغيلا" تصنف ضمن البكتيريا عفوية الشكل، وإن أعراضها الشائعة تبدأ بنزلات معوية، وتصيب الأطفال في معظم الأحيان.
وأضاف لنشرة أخبار رؤيا، الأربعاء، أن البكتيريا تدخل إلى جسم الإنسان من مجرى الجهاز الهضمي، عن طريق الطعام والشراب، مشيرا إلى أن أعراضها تبدأ بالغثيان وارتفاع درجات الحرارة والإسهال، في حين يمتاز تشخيص جرثومة "شيغيلا"، بالإسهال المصحوب بالدم.
ولفت إلى أن طرق العلاج من جرثومة "شيغيلا"، تكون بالسوائل والمحاليل الوريدية، لافتا إلى أن أعراضها قد تتطور لتصبح "متلازما تحلل الدم"، وهي نادرة الحدوث وفق الطراونة.
وحول تسسبها بالوفاة، أوضح الطراونة أنه في بعض الحالات النادرة قد تقود "متلازما تحلل الدم اليورينية"، للدخول إلى أقسام العناية الحثيثة في المستشفيات، أو تتسبب بالوفاة.
وتابع أن جرثومة "شيغيلا" في بعض الأحيان تكون شديدة العدوى، مبينا أن طرق الوقاية منها تكون بالحفاظ على النظاقة الشخصية، وغسل اليدين بالماء والصابون لمدة لا تقل عن 20 ثانية، وتجنب تناول الغذاء بشكل مشترك في التجمعات السكنية، والمخيمات الكشفية، والمعسكرات، والسجون.
وكان مساعد أمين عام وزارة الصحة لشؤون الأوبئة الدكتور غازي شركس قال الأربعاء، إن النتائج الأولية للعينات المأخوذة من الأشخاص الذين أصيبوا بحالة تسمم في قرية جبة في محافظة جرش، سببها جرثومة الشيغيلا.
وأكد شركس في تصريح لـ"رؤيا"، في أثناء زيارته إلى المرضى في مستشفى جرش الحكومي، أن نتائج العينات تشير إلى وجود جرثومة الشيغيلا التي نتج عنها اشتباه تسمم نحو ما يقارب 57 شخصا، منذ ظهر يوم الاثنين الماضي.
ولفت إلى أن فرق الوزارة قامت بجمع العينات، وتعبئة الاستبيان الخاص بمثل تلك الحالات للوصول إلى النتائج الأولية، مؤكدا استمرار الفحوص للتوصل إلى السبب الرئيسي.
ووفقا لـ"مايو كلينيك"، فإن جرثومة الشيغيلا هي عدوى معوية تسببها فصيلة بكتيرية تعرف باسم الشيغيلا. ومن أهم العلامات الدالة على الإصابة بها الإسهال. كما أنها معدية جدا ويصاب بها الأشخاص عند ملامسة كميات صغيرة من البكتيريا من براز شخص مصاب.
وكان مدير مستشفى جرش الحكومي الدكتور صادق العتوم، قد صرح لـ"رؤيا" بان حصيلة المصابين بحالة التسمم وصلت لغاية ساعات صباح اليوم الأربعاء إلى 57 حالة، وبأن جميع المرضى حالتهم الصحية مستقرة.